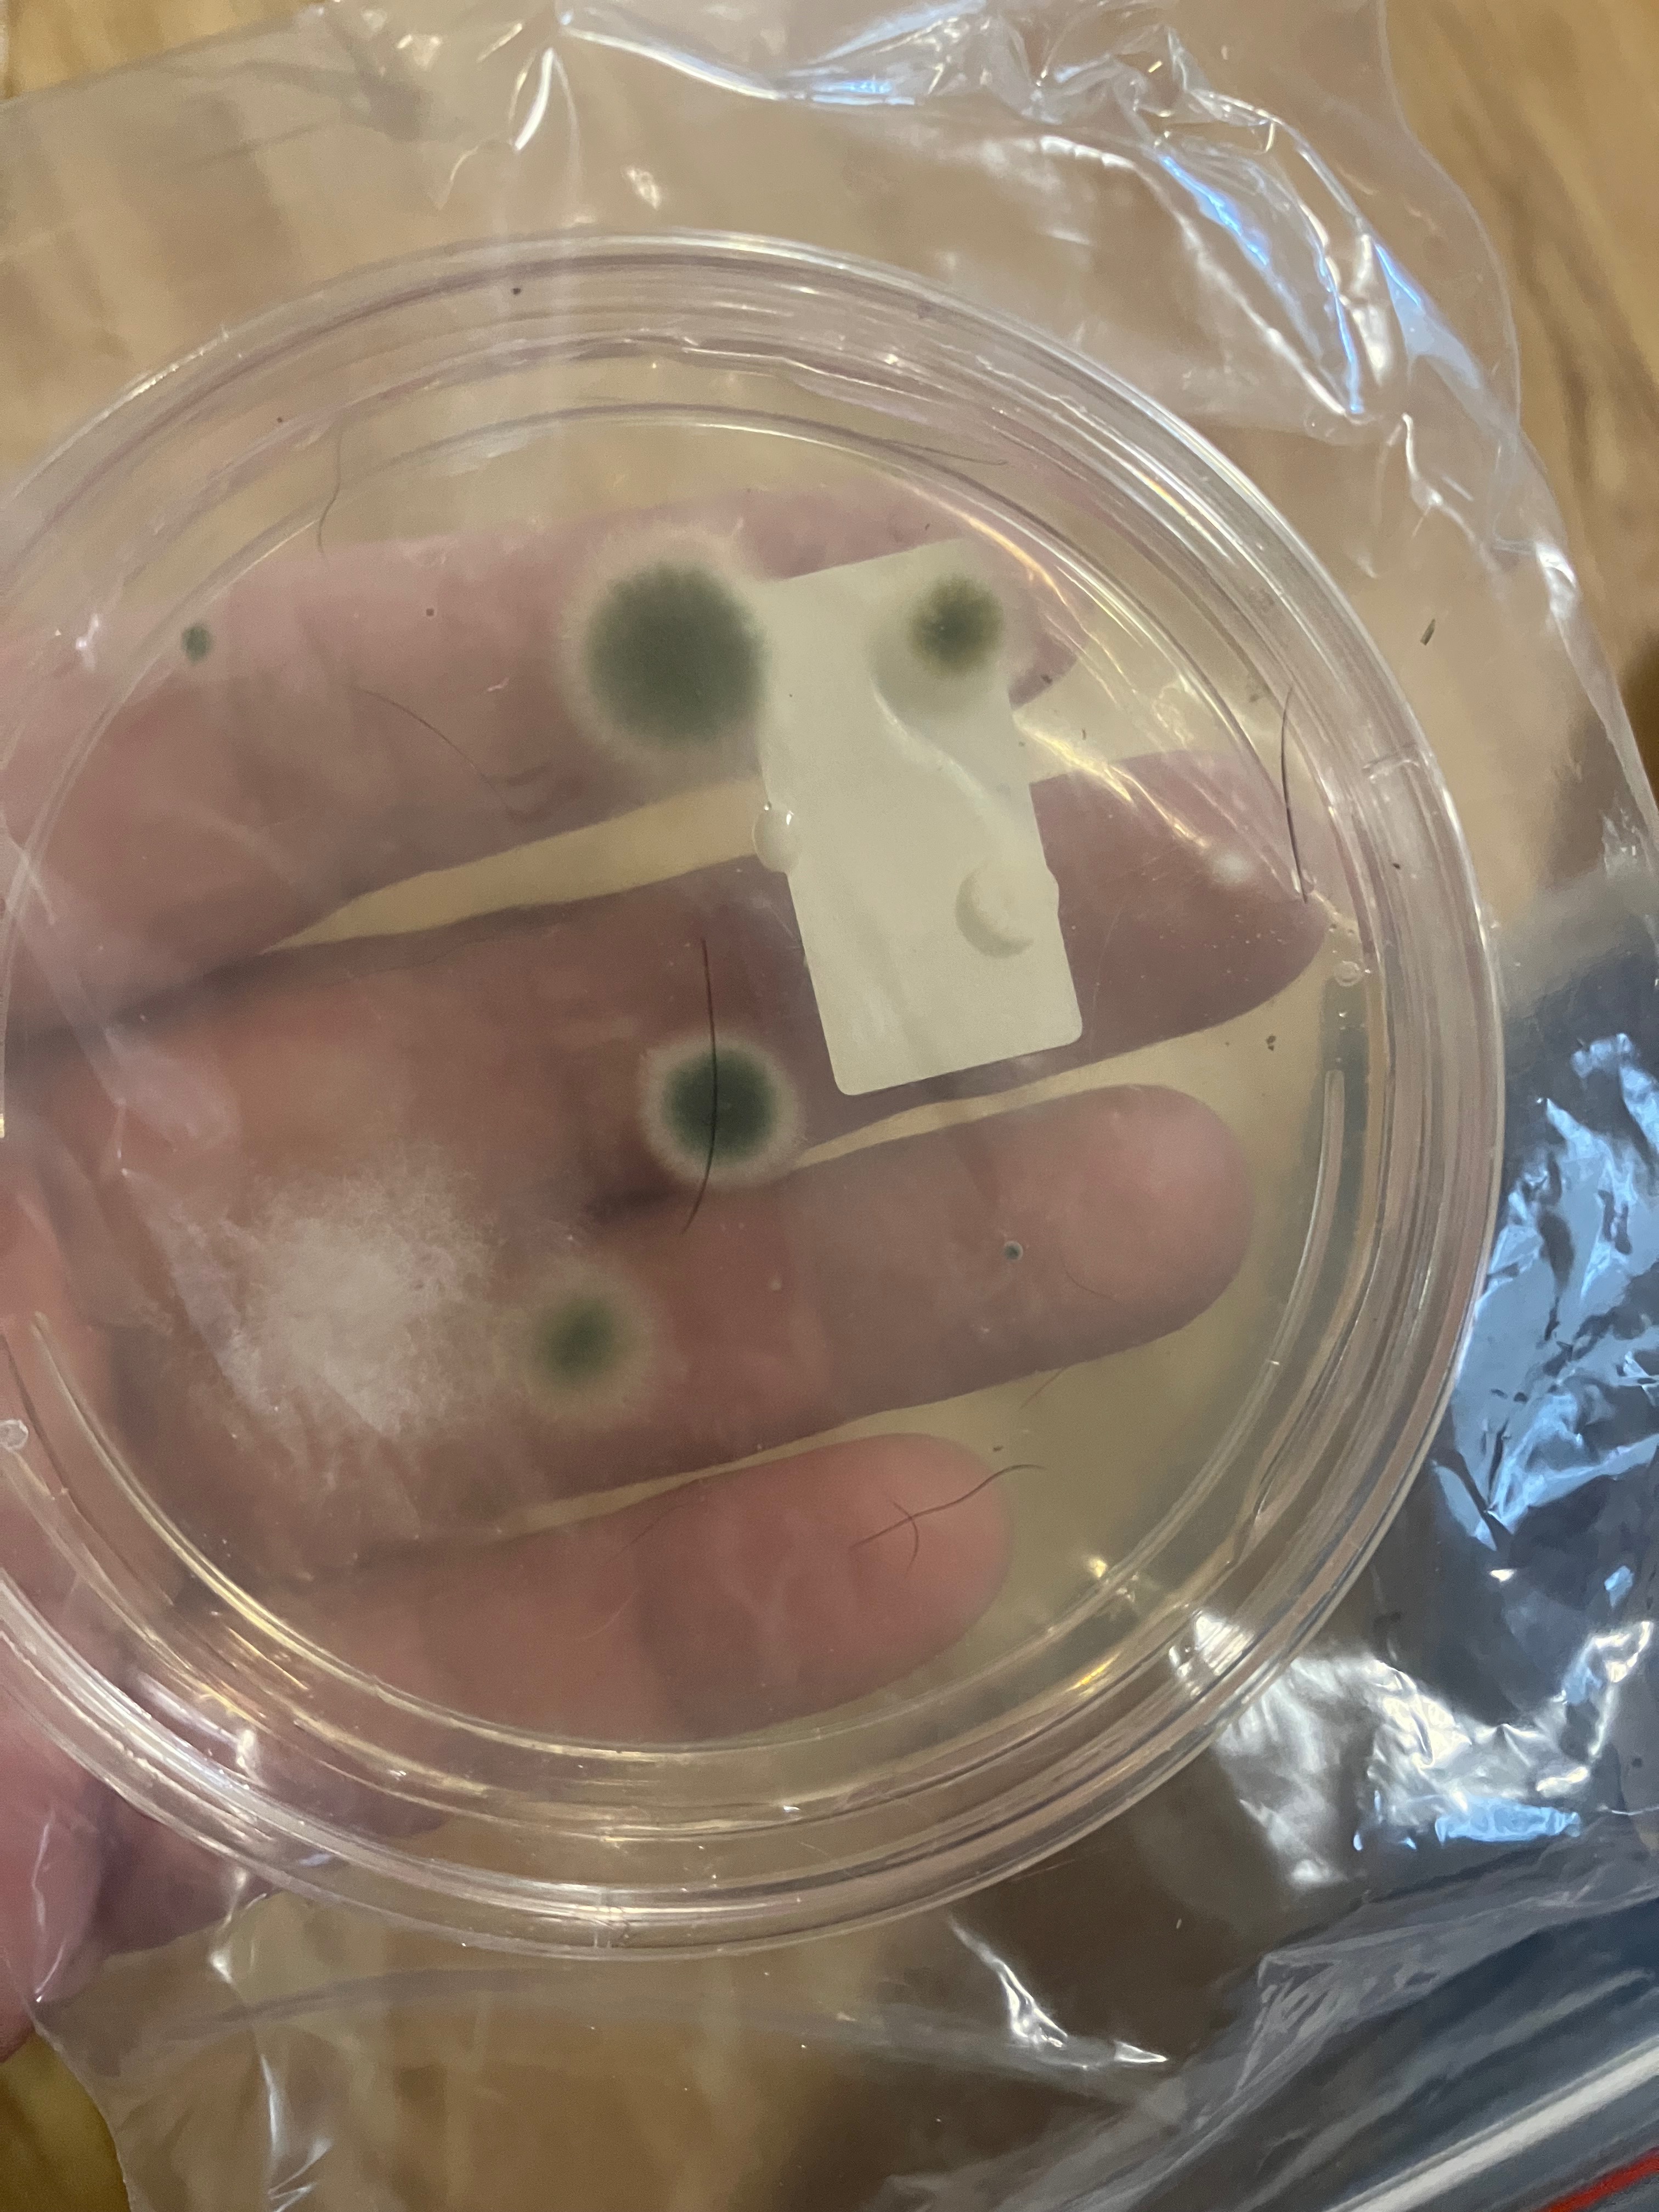

Hello, my name is Tricia. I hate having to do something like this, but I don’t have many options. I’m a single mom; I have 2 daughters that live with me, 16 and 13 years old. We moved into our current rental house in May 2025. In June, I noticed my asthma was a little worse than normal. At the end of July, I ended up in the emergency room with pneumonia. The start of my long journey of breathing issues. Since then, I have had numerous doctor visits, some emergency room visits due to shortness of breath and having a hard time breathing. I found mold in my basement; the landlord was informed, I was told mold can’t kill you, that I must have sleep apnea, and it’s all in my head. I have been tested in the past, and it was found that I am allergic to mold. I also have asthma. My doctor has referred me to an allergist, an immunologist, and a pulmonologist. I don’t like asking for help. But given the circumstances, I am needing to move into a place that is safe to live in. The money would be going towards the damage deposit and first month's rent. Anything extra would replace furniture we would need to get rid of. Thank you in advance.